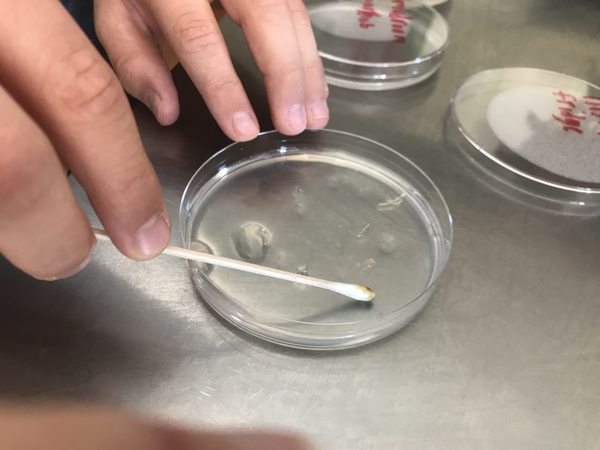
Bacteria science experiments are great for middle and high school students! #homeschool #science #homesciencetools
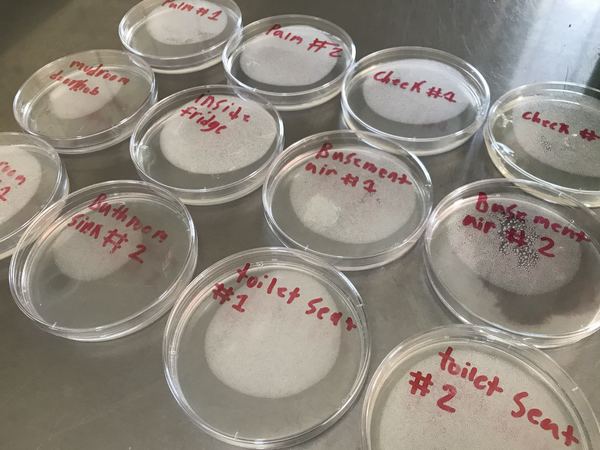
Bacteria science experiments are great for middle and high school students! #homeschool #science #homesciencetools
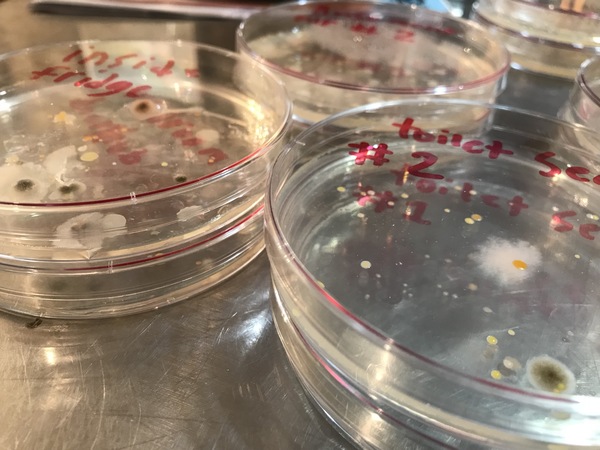
Bacteria science experiments are great for middle and high school students! #homeschool #science #homesciencetools
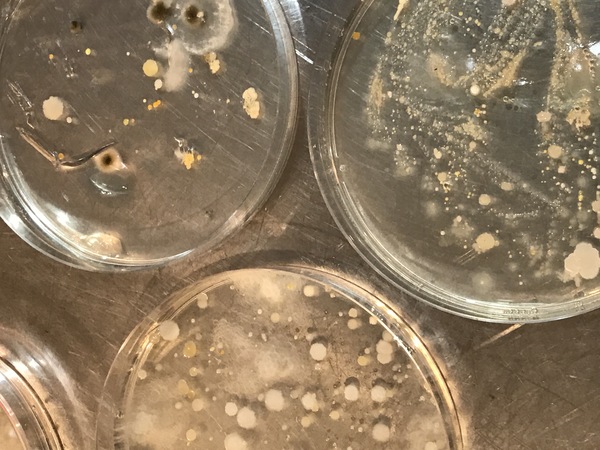
Bacteria science experiments are great for middle and high school students! #homeschool #science #homesciencetools
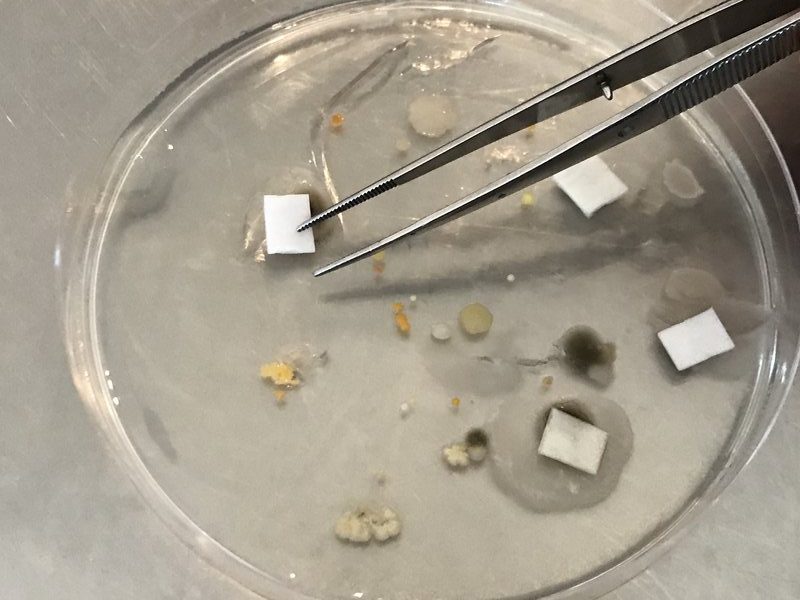
Bacteria science experiments are great for middle and high school students! #homeschool #science #homesciencetools

Bacteria Science Experiments: What’s Growing in Your Homeschool?
Ah, fall. Beautiful weather, fun festivals, football…and the beginning of “sick season.” It’s the perfect time of year to teach middle and high school students about germs through some cool bacteria science experiments!
I’ve harped to my son for years about the importance of hand-washing to prevent illness. Now that he has actually seen bacteria with his own two eyes, he’s washing his hands more often. It’s incredible what experiential learning can teach.
Bacteria are all around us—and not all of them are bad! Good bacteria are essential in our bodies to help us digest food and fight off some of the bad microbes that get in. Additionally, bacteria are fabulous decomposers in our world and help us clean up dead things.
Bad bacteria, sometimes called pathogens, are harmful and can cause illnesses like strep, meningitis, Lyme disease, or salmonella poisoning.
We certainly can’t hide from all pathogens, but as Eli and I learned through our bacteria science experiments, hand washing can go a long way toward keeping them at bay.

I received complimentary products and compensation from Home Science Tools in exchange for writing this post. As always, my opinions are strictly my own. Affiliate links are included in this post.
Making Bacteria Cultures At Home
Way before we concluded that hand washing is essential for wellness, we started at the beginning with two questions.
- What is bacteria?
- How do we know it’s really there if it isn’t easily observed?

I ordered the Bacteria Growing Kit from Home Science Tools to help us understand bacteria. It had enough supplies to culture several bacteria samples from the air, on surfaces, and our bodies.
To “culture bacteria” means to collect samples of bacteria (or suspected bacteria) and place them in a sterile petri dish prepared with an agar solution. The agar acts as a nutrient to help the bacteria reproduce so that it can be more easily observed and identified.

The Bacteria Growing Kit allowed us to prepare 20 of our own Petri dishes with the agar solution—a cool activity in and of itself. Following detailed instructions, we captured two bacteria samples from the air, labeled the Petri dishes, and stored them in a dark place for a week to allow the bacteria to colonize—or grow.
One of the Petri dishes became the control, while several sensitivity squares soaked in various antibacterial chemicals were placed on the bacteria colonies in the other petri dish. After a few more days, both petri dishes were observed and conclusions were drawn based on a few leading questions provided in the direction guide.

Similarly, experiments were completed for other bacteria samples where we swabbed household surfaces like door knobs, a bathroom sink, a toilet seat, and inside the refrigerator.
There were plenty of extra Petri dishes that allowed for other interest-based cultures, too. A fun list of experiment ideas was included. My favorite prompted us to make two cultures from swabbing the inside of Eli’s mouth. One culture was grown from a swab before using mouthwash, and the other was grown from a swab after using mouthwash. Eli had to note the differences to see if mouthwash significantly affected mouth bacteria.
While the kit didn’t help us identify the bacteria colonies we had grown or whether they were good or bad, it definitely impacted understanding! (If you have a microscope, you could make slides and try to identify the samples from internet research.)
Most of the necessary supplies came with the kit. I had to provide disposable gloves, tweezers, and a few disinfectant chemicals, such as bleach, hand sanitizer, vinegar, and essential oils, to soak the sensitivity squares. It’s no biggie.
Please Note: Colonized bacteria can be dangerous. It’s VERY important to follow the kit directions closely and adhere to all the safety precautions.
Hand Washing Bacteria Science Experiments
We completed a culture of the bacteria on our hands using the Bacteria Growing Kit, but I wanted to emphasize the importance of hand washing. I also ordered the Bacteria Hand Washing Experiment Kit from Home Science Tools.
It followed the same basic process that I mentioned above. We prepared our Petri dishes with agar solution and then collected bacteria swabs to culture.

The difference is that these experiments are highly focused on testing the effects of hand washing with various soaps and sanitizers.
Five helpers were necessary as one petri dish was swabbed with bacteria from each person before their hands were washed, and another swab was taken after their hands were washed with one of the soaps or sanitizers we chose to use. Hypotheses were made as the Petri dishes were placed in a warm, dark place for a week.
The colonized petri dishes were examined for various colonies of bacteria, and a chart was completed to document the results. That chart helped us determine which soap was most effective in killing bacteria.
It’s important to note again that good bacteria are on our hands sometimes. I followed this experiment by asking Eli to research the pros and cons of antibacterial soaps/sanitizers vs. regular soap. Based on the bacteria science experiments and his research, he’s decided that hand washing with soap is indeed very important. However, it’s probably best to use regular old soap and water over antibacterial supplies as they tend to kill off too many good guys.
Hands-On Bacteria Science Experiments
As homeschoolers, it’s easy to read science texts and skip the experiments altogether. Even if we think experiments have value, it’s easy to believe watching a YouTube video of someone else doing the experiment is enough.
I get it. Experiments require extra time and effort. We have to gather supplies and clean up messes. Maybe even more importantly, we don’t often know what we’re doing or how to explain it.
But over the years, I’ve seen the importance of hands-on science experiments. They solidify understanding much like working with manipulatives does for math concepts. They also promote scientific thinking, like thinking, orderly thinking, and discovery-based learning.
Science experiments require higher-order thinking skills. We should always strive to give our children opportunities to practice these skills—application, creation, evaluation, and analysis—because that’s where the real understanding and meaning in learning are!
That’s why I love Home Science Tools. They not only make science experiments easy by providing inexpensive kits, but they typically provide great directions and explanations.
Bacteria, Fungi, and Viruses
While bacteria, fungi, and viruses are not the same, they are good topics to study together since our bodies can be affected by each. These books can help!
While not about the human body, you can certainly study fungi in nature, too. NaturExplorers A Fungus Among Us helps you turn nature study into an inquiry-based, hands-on science lab!
And finally, here are a few of my previous posts that may interest you, too.







Shared on Facebook.com/www.capturingthecharmedlife